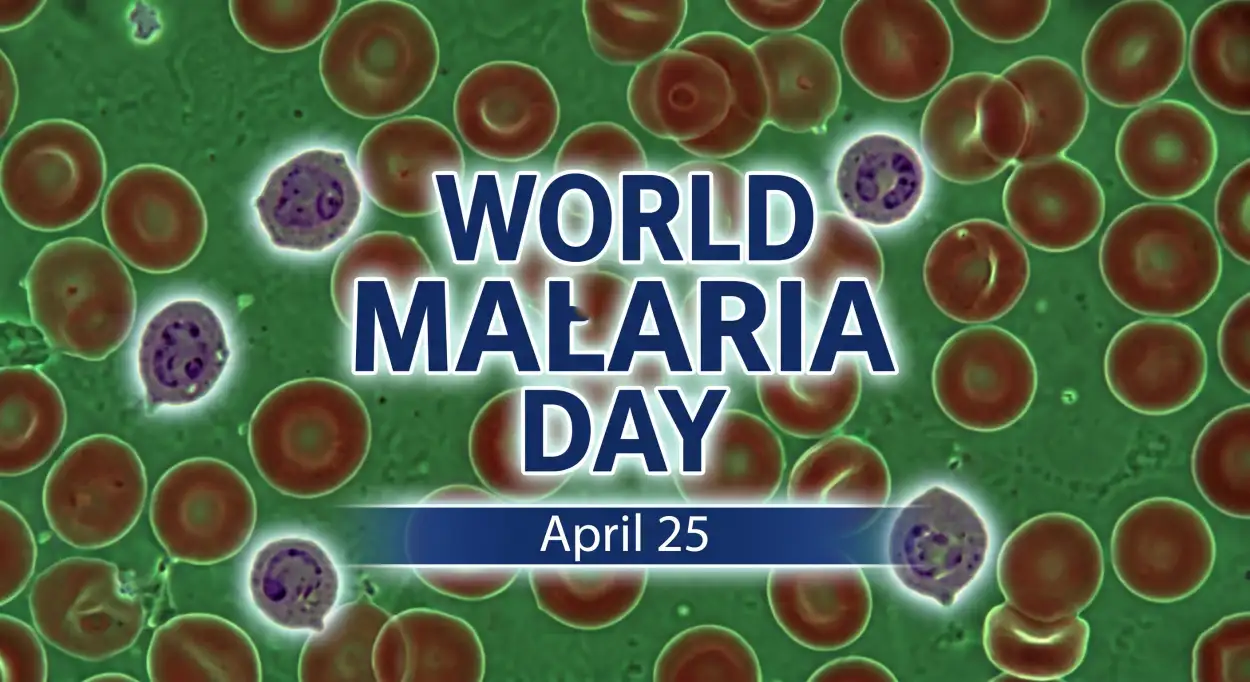
Free Download World Malaria Day 2026 Campaign Poster Design - High Quality World Malaria Day 2026 Image

Free World Malaria Day 2026 Campaign Poster Design HD Download
Download this high-quality World Malaria Day 2026 Campaign Poster Design image, perfect for world malaria day 2026, social media posts, festival greetings, event designs, banners, and creative projects. Clean quality, ready to use, and easy to customize.
Click to get original high-quality image 👇
Free Download
✅ No Login • ✅ 100% Free • 🔥 21+ Downloads































































































